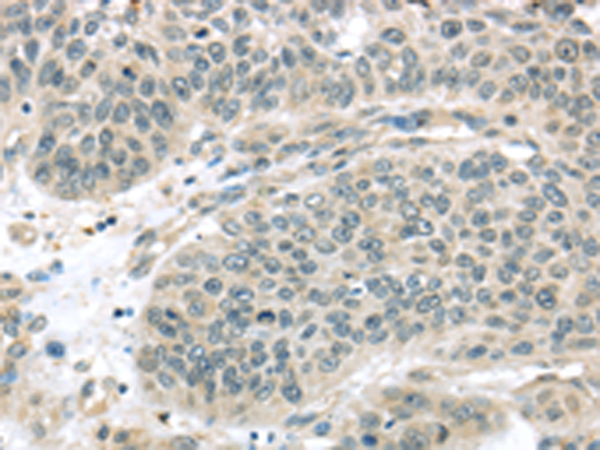

|
Background: |
THAP domain-containing protein 4 is a protein that in humans is encoded by the THAP4 gene. |
|
Applications: |
ELISA, WB, IHC |
|
Name of antibody: |
THAP4 |
|
Immunogen: |
Fusion protein of human THAP4 |
|
Full name: |
THAP domain containing 4 |
|
Synonyms: |
PP238; CGI-36 |
|
SwissProt: |
Q8WY91 |
|
ELISA Recommended dilution: |
2000-5000 |
|
IHC positive control: |
Human lung cancer |
|
IHC Recommend dilution: |
25-100 |
|
WB Predicted band size: |
63 kDa |
|
WB Positive control: |
293T cell |
|
WB Recommended dilution: |
500-2000 |
購物車
幫助
021-54845833/15800441009
